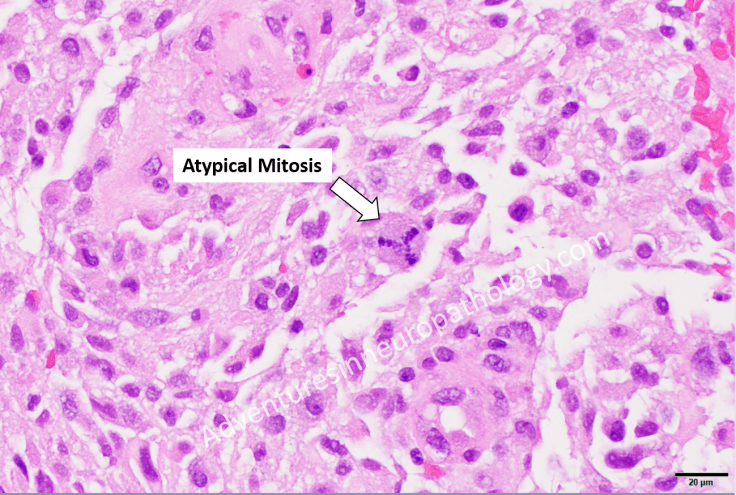
GBM with atypical mitoses

Cell division occurs in four major stages (prophase, metaphase, anaphase, and telophase) during which DNA duplicates itself and condenses, chromosomes centrally align and are pulled apart by two centrosomes on either side of the cell, and the cytoplasm separates to form two separate daughter cells. Cancer cells are able to enter into cell division by bypassing the usual complex ballet of cell signaling networks and rigorous checkpoints that prevent aberrant replication and propagation of abnormal DNA. The abnormal mitosis detected within this glioblastoma is a tripolar metaphase cell that likely has 3 (or more) centrosomes present. Neoplastic cells with mitotic multipolarity often have wide copy number variability and significant cytogenic aberrations; these features contribute to the aggressiveness and lethality of IDH-wildtype glioblastoma, in that many patients succumb to the disease within 2 years of diagnosis despite maximal treatment.

Leave a comment